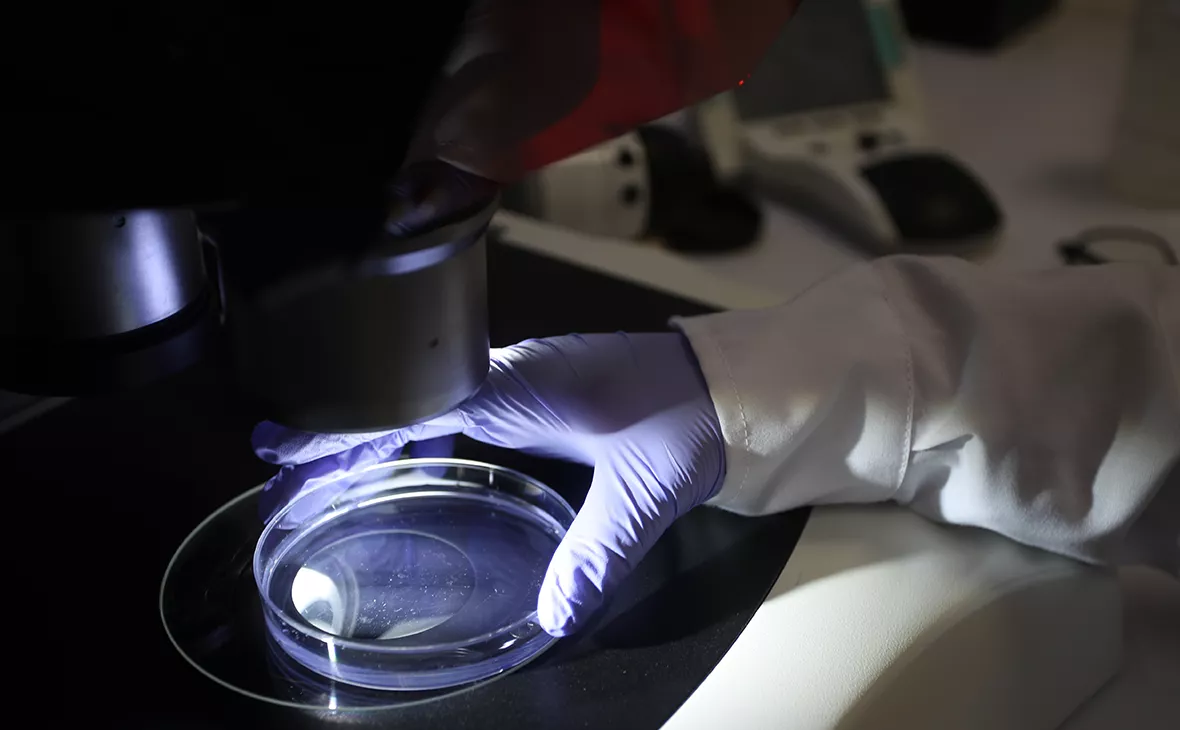
Raul Sifuentes / Getty Images

Ученые обнаружили в России новый штамм коронавируса «русский дельтакрон»
При исследованиях в Петербурге был выявлен новый вариант коронавируса, который пока не был замечен в других странах, — гибрид «омикрона» и «дельты»
Фото: Raul Sifuentes / Getty Images
Исследователи обнаружили в России новый вариант коронавируса, который представляет собой гибрид штаммов «омикрон» и «дельта». Опасность «российского дельтакрона» еще предстоит изучить, рассказал РБК американский ученый-генетик Дмитрий Прусс.
Штамм коронавируса «дельта» был впервые описан в Индии в конце 2020 года и некоторое время был доминирующим в большинстве стран мира. Однако в 2021 году его начал быстро вытеснять более заразный штамм «омикрон», впервые выявленный в Южной Африке. В итоге именно этот штамм, более заразный и вызывающий в большинстве случаев менее тяжелое течение болезни, стал доминирующим. В июне Роспотребнадзор сообщал, что на «омикрон» приходится почти 98,3% всех выявляемых в стране случаев COVID-19.
Как рассказал РБК Прусс, вирусы, сочетающие в себе фрагменты геномов «омикрона» и «дельты» — это большая редкость, поскольку штамм «дельта» практически исчез. «Однако именно такие необычные гибридные вирусы обнаружили в последних загрузках геномных данных из Петербурга. Первые из них появились в базах в начале июля, и были встречены с легким недоверием. Но к концу июля исследователи из Института гриппа имени Смородинцева нашли еще больше таких геномов. Перепроверили все, что могли, и пришли к уверенному выводу: это не ошибка, а действительно гибридный вирус», — рассказал ученый.
Ни в одной другой стране мира этот вид коронавируса пока не был выявлен, отмечает Прусс, поэтому, вероятнее всего, его родина — Россия. Тем не менее распространенность штамма пока невелика, по крайней мере в Петербурге, где проводил исследования Институт гриппа.
«Опасен ли недавно открытый «русский дельтакрон», еще предстоит определить. Неизвестно, может ли он вытеснить другие штаммы. Неизвестно также, может ли он вызвать тяжелый ковид. У исходной «дельты» есть способность поражать легкие, которая ослабла у «омикрона», но как это передастся гибриду? Лучшее, что я бы посоветовал российским медицинским организациям, это усилить отслеживание новых штаммов. Тут и более активное прочтение геномов нужно, и более прозрачная отчетность с загрузкой в мировые базы, и даже случайное тестирование на ковид. Без этого недостаточно данных, чтобы сказать, не пора ли добавить мер эпидемиологического контроля», — констатирует Прусс.
Вирусолог, профессор МГУ, доктор биологических наук Алексей Аграновский в разговоре с РБК также отметил, что пока что говорить о свойствах новой химеры, или «дельтакрона», рано. «Новые варианты должны быть предметом тщательного изучения специалистов. Данные сведения о химере SARS CoV-2 получены на весьма ограниченной выборке, о свойствах рекомбинантов пока судить рано», — подчеркивает он.
По словам Аграновского, возникновение таких гибридов вполне возможно при высокой доле зараженного населения. «Вирус меняется за счет двух механизмов: внесения мутаций и рекомбинаций (перетасовки кусков РНК генома). Чем больше актов репликации (попросту, чем больше зараженных людей в популяции), тем выше шанс возникновения новых вариантов, которые могут получить преимущество и закрепиться», — объясняет он.
Сообщения о появлении гибридов «дельты» и «омикрона» появлялись и раньше. В январе об обнаружении «дельтакрона» сообщали кипрские ученые. У него была одна генетическая основа с «дельтой» и одновременно были мутации, характерные для «омикрона». Однако выявлен этот гибрид был всего у 25 человек. В связи с этим возникли предположения, что «дельтакрон» был лабораторной ошибкой — результатом загрязнения образца вируса, взятого для секвенирования. Этой точки зрения придерживалась глава технической группы подразделения чрезвычайных заболеваний Всемирной организации здравоохранения Мария ван Керкхове. Не исключали такую возможность и российские вирусологи.
Первой на появление исследования о гибриде «омикрона» и «дельты» обратила внимание ведущая программы «Посоветуйте, доктор» Ольга Копылова в своем Telegram-канале.









